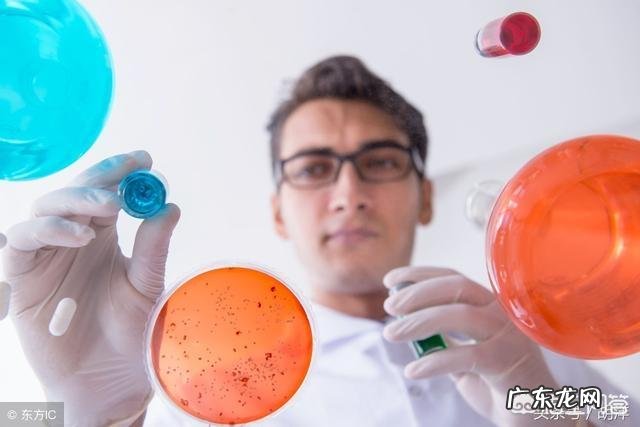
糖是癌细胞的主要食物,肿瘤患者还能吃糖吗?

糖确实是癌细胞的主要食物 , 癌细胞对糖有特殊的嗜好 。癌细胞不像一般正常细胞那样依靠有氧呼吸、氧化磷酸化供能 , 而是主要依靠糖酵解作用为生 。这些肿瘤细胞分解糖的能力非常强盛 , 约为正常细胞的20倍 。如果使血液流过肿瘤 , 约有57%的血糖被肿瘤消耗掉 。
文章插图
诺贝尔奖得主奥托沃伯格提出 , 肿瘤细胞的生化特征是糖代谢从氧化磷酸化向无氧酵解转变 , 即沃伯格效应 。其实这也是癌细胞进化过程中获得的生存本领 。由于癌细胞生长迅速 , 肿瘤组织长期处于缺氧状态 , 从而无氧酵解增强 。但令人讨厌的是 , 癌细胞的糖酵解产能很少 , 使得糖造成极大的浪费 , 不仅产能少 , 还生成大量的乳酸 , 这些代谢产物对正常细胞没有任何用处 , 却对癌细胞有极大的用处 。与氧化磷酸化相比 , 糖酵解有利于肿瘤细胞的快速增殖 , 肿瘤细胞通过糖酵解获取中间代谢产物 , 比如乳酸 , 用于合成脂肪、蛋白质和核酸 , 以满足自身活跃的合成需要 。

文章插图
如果这样 , 是不是肿瘤患者不能吃糖了?

文章插图
目前没有任何研究明确表明:遵循‘无糖’的饮食 , 可以降低患癌症的风险 , 或者是延长癌症患者的生存期 。这是因为糖是人体的最基本的燃料 , 所有正常细胞的运转能量主要来自于糖 , 尤其是心、脑、肺、肝、肾等重要脏器 。比如低血糖的时候 , 人会出现头晕、心慌、出冷汗甚至昏迷 。除此之外 , 无糖饮食根本不存在 , 除了糖本身 , 米、面等淀粉类主食最终都是消化分解为糖 , 而且人体内的糖可以来自任何食物 , 哪怕它只含有蛋白质和脂肪 , 身体内的细胞也会通过糖异生帮助你把他们转换成葡萄糖 。含有碳水化合物的食物也是纤维素和维生素的良好来源 。
所以肿瘤患者不需要过分担心吃糖带来的危害 , 癌症患者由于体质弱 , 食欲较差 , 尤其是晚期患者 , 有不同程度的营养不良 , 加强营养显得尤为重要 , 不需要过度控制糖的摄入 , 而且有必要吃足够的主食 , 以保证能量供应 。合并糖尿病的癌症患者需要适当控制糖的摄入 , 晚期癌症患者即便有糖尿病 , 为防止低血糖发生 , 也不能过分减少糖和主食 。肿瘤患者的饮食原则是:均衡饮食 , 除了足够的主食之外 , 增加鱼肉蛋奶等蛋白质摄入 , 多吃水果蔬菜 。
糖尿病人偶尔想吃一些甜食 , 允不允许呢?谢谢邀请!我是福爸 , 临床营养师 , 专注体重管理、疾病营养zhi疗和母婴营养 , 希望我的回答对您有益 。

文章插图
糖尿病人最担心的就是吃东西之后血糖升得厉害 , 所以让我们先看看吃什么样的东西 , 对餐后血糖的影响会比较大 。这里我们要介绍两个指标 , 一是食物含碳水化合物的数量 , 二是血糖指数 。碳水化合物的数量决定了餐后血糖升高的程度 , 血糖指数决定了餐后血糖升高的速度 。而食物的甜度反而和血糖没有直接的关系 。
- zhi疗白头发,是黑豆效果好,还是黑芝麻效果更好?
- 在西方绘画史上,有哪些绘画作品表现的是爱情婚姻的意义
- 162CM的女生标准体重是多少啊
- 零食,真的是小朋友的“禁区”吗
- 豆腐脑吃咸的甜的还是原味的
- 吃减肥糖果对身体有害吗?
- 吸引力法则是真的吗?为何?
- 你知道哪些男明星是减肥成功的?他们如今的现状怎么样?
- 韩国有种黄色小包装水说是排毒对皮肤好有人知道这个产品吗?
- 夹板是否可以用呢?
特别声明:本站内容均来自网友提供或互联网,仅供参考,请勿用于商业和其他非法用途。如果侵犯了您的权益请与我们联系,我们将在24小时内删除。
